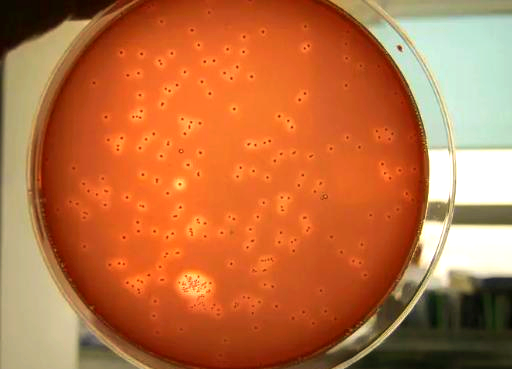
1753840172140163.png

本内容由山西华芙兰生物技术有限公司提供技术咨询
有人说现在这个阶段不能使用乳酸菌?
原因就是“乳酸菌菌液发酵后是酸性的,使用后容易使得池塘里面的硫化氢毒性增强”,这个是完全没有依据的!
首先我们需要知道,高温天之所以容易产生硫化氢,就是因为底部的垃圾太多,加上底部溶氧普遍偏低,代谢慢,有些塘口还有烂草,这些综合因素所导致的。一般出现硫化氢之后,我们解决的方法:水源好的话,可以通过换水稀释水体里面的脏东西,同时能有一定增氧作用;再有就是改底,改底的主要目的就是辅助把底部的垃圾处理掉,然后必须要有的就是下菌,进行正常的维护。所以池塘里面硫化氢超不超标,这个完全是跟底部垃圾,溶氧挂钩的。

我们现阶段使用乳酸菌,大剂量下的原因主要就是辅助分解水体里面的有机质,减少有机质沉降,进而进一步的减轻池塘底部的代谢压力,同时大剂量下,还可以起到补充水体碳源,抑制蓝藻的作用,所以这个跟硫化氢超标完全没有关系,不仅没有关系,定期下乳酸菌的话,在一定程度上还可以减少硫化氢的滋生。所以乳酸菌是可以用的,只是不建议长期单一使,使用的时候可以结合光合菌交替着来,这样池塘的有益菌群可以更协调的发挥作用,净水效果会更明显一些!

CopyRight © 山西华芙兰生物技术有限公司【官网】  豫公网安备41078202000740号
豫公网安备41078202000740号
 豫ICP备2025132585号 | 技术支持: 郑州非特网络技术有限公司
豫ICP备2025132585号 | 技术支持: 郑州非特网络技术有限公司